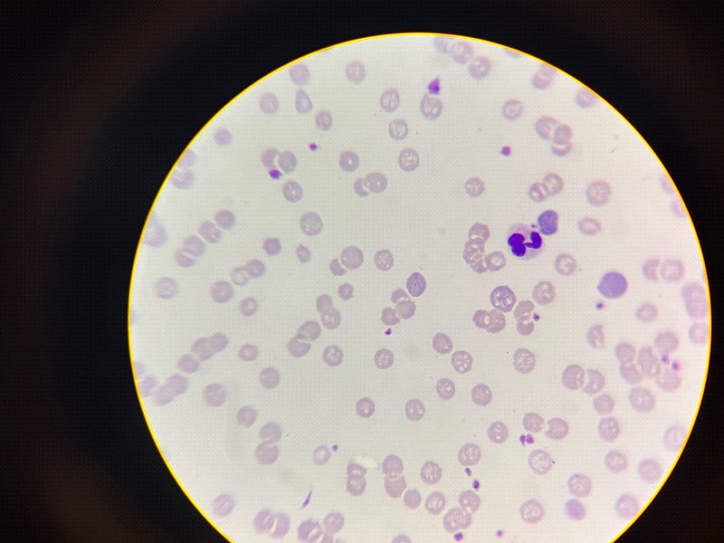

Ветеринарная конференция “Summer Vet Meeting” в Челябинске.
С 20 по 21 августа большая часть наших сотрудников посетили ветеринарную конференцию “Summer Vet Meeting”, которая прошла в Челябинске и на которой собрались основные практикующие доктора со всей Челябинской области.
Первый день был лекционным и посвящен актуальным темам, необходимым в каждодневной практике:
- как могут запутать лейкоциты;
- изменения концентрации калия и кальция – взгляд эндокринолога;
- как начать смотреть цитологию в условиях маленькой клиники;
- атопический дерматит – не так прост, как кажется;
- ВИК - патогенез, диагностика, клинический подход.
Во второй день проходили мастер-классы:
- «Клинический подход к анемиям» c участием Шишкановой Светланы Викторовны-руководителя ветеринарной лаборатории Поиск, клинический патолог, где узнали много нового об изменениях морфологии эритроцитов при различных заболеваниях;
- «Непонятная кошка на приёме и когда врачу не важны ретровирусы» c участием Владислава Скороходова, ВК "В добрые руки", на котором подробно разобрали патогенез, диагностику, клинический подход к вирусным заболеваниям и разобрали как продлить жизнь кошкам с установленным диагнозом.
Большое спасибо организаторам, лекторам и руководству клиники за возможность изучать больше нового и полезного материала, и развиваться в лабораторной диагностике. Данное обучение дало возможность освежить уже имеющиеся знания, а также узнать много нового в лабораторной диагностике, так как для постановки правильного диагноза и назначения корректного лечения необходимы верно выполненные исследования.
Лаборант УВЛ
Тракторозаводского района
Дарья Андреевна Пономарева